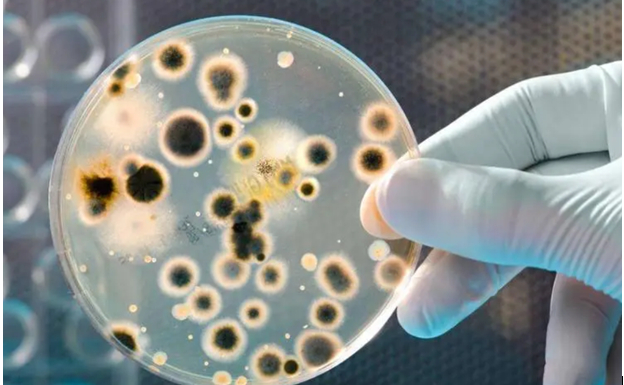

转自:药事纵横
微生物数据偏差是指微生物检验结果超出了药典、GMP法规或企业建立的产品质量标准或可接受标准。包括但不限于环境和水质检测、清洁验证过程以及原料、制剂中间过程和成品检测中产生的结果。
一、制药企业微生物偏差的调查应该包括以下步骤:
定义微生物数据偏差:制定清晰的微生物数据偏差定义和分类,包括对异常结果的定义、原因和影响的分析。
收集数据:收集与微生物数据偏差相关的所有数据和文献资料,包括检验报告、验证报告、质量控制记录等。
初步调查:对微生物数据偏差进行初步调查,了解发生时间、频率、范围、影响等方面的情况,可以采用根本原因分析(RCA)等方法。
分析数据:对微生物数据进行分析,使用统计方法分析原始数据,以确定数据是否具有显著性。
寻找根本原因:针对微生物数据偏差进行更深入的调查,确定根本原因,可以采用鱼骨图、5W1H等分析方法。
制定纠正和预防措施:确定根本原因后,制定纠正和预防措施,并在质量管理系统中实施和记录这些措施。
评估措施效果:对实施的措施进行评估,以确保问题得到彻底解决,并记录所有评估结果。
二、阶段I的微生物实验室调查
实验室调查的目的是建立检验结果的有效性,从而确认已经发生了偏差。如果已发生实验室错误致使检验无效,QC部门将批准对活性成分或成品/原料药进行复检和/或重新取样。企业QC微生物实验室大小和复杂性各有不同。这些因素可能影响分析员和实验室管理人员在培训、经验和学术背景方面处理偏差的经验水平。具体执行过程可以参考FDA行业指南——制药生产OOS结果调查进行。

实验室调查中最重要的两个调查指标包括超标菌种鉴定情况和实验室的无菌室管理水平。
1、菌种鉴定:
实验室菌种鉴定是指对实验室中分离出的微生物进行分类和鉴定,以确定其种属、亚属和菌株等信息。菌种鉴定可以帮助实验室进行微生物检测和质量控制,确保实验室中的微生物工作符合标准和要求。
以下是实验室菌种鉴定的一般步骤:
分离纯菌:首先需要从样品中分离出单一的菌落并进行纯化,以避免不同菌种混杂导致的鉴定错误。
形态特征观察:观察菌落的形态、大小、颜色、质地等特征,以及细胞形态、结构和运动特征等,初步确定菌种的类别。
生理生化特性测试:进行一系列生理生化特性测试,包括碳源利用、氧气需求、酸碱度耐受性、代谢产物等等,以进一步确定菌种的特征和类别。
分子生物学鉴定:可以采用PCR、DNA测序等分子生物学技术对菌种进行鉴定,通过比对菌株的16S rRNA序列和其他基因信息与数据库中的菌株进行比对,确定菌种的种属、亚属和菌株等信息。
确定菌株存储方式:根据菌种的特性和存储需求,选择适当的菌种保存方法进行保存,如冷冻保存、干燥保存、液氮保存等等。
实验室菌种鉴定是一个复杂的过程,需要多种方法和技术的综合应用。在进行菌种鉴定之前,需要准备充分,并建立完善的菌种鉴定流程和标准。
2、实验室的无菌室管理水平
2.1无菌室内物品要求
所有需入无菌室操作使用的培养基及缓冲液,包括:硫乙醇酸盐流体培养基,胰酪大豆胨液体培养基,pH7.0无菌氯化钠-蛋白胨缓冲液等,都必须经高温高压蒸汽灭菌后,方可移入无菌室传递窗内备用。所有需入无菌室操作使用的用具,器皿,包括:培养皿,剪刀,摄子,注射器,滤器,注射用水等,都必须经高温高压蒸汽灭菌或高温干热灭菌后,方可移入无菌室传递窗内备用。已洗涤的无菌衣,裤,帽,口罩均需装入无菌袋后,经高温高压蒸汽灭菌后,方可移入无菌室缓冲间内备用。无菌检验用75%乙醇灭菌药棉,无菌用酒精灯,无菌用盛水器及盛废弃物容器等均需表面消毒入无菌室传递窗内备用。
2.2无菌室消毒
按照GMP的要求每周一次应对无菌室进行大消毒,用消毒剂擦洗消毒,开启紫外灯。擦拭方法:用无纺布浸渍消毒溶液清洁超净台的整个内表面、顶面、及无菌室、人流、物流、缓冲间的地板、传递窗、门把手以及无菌室内放置物品。清洁消毒程序应从内向外,从高洁净区到低洁净区。逐步向外退出洁净区域。然后开启无菌空气过滤器及紫外灯杀菌1~2h,以杀灭残留微生物。在每次操作前及操作后,同样用上述消毒溶液擦拭工作台面,并开启紫外灯杀菌。无菌室内拖鞋先用洗涤剂清洁,再用消毒剂浸泡30分钟后,以备使用。
按照GMP的要求每周一次清洁回风口的滤网:拆下回风口的滤网,先用自来水冲洗,后用纯化水冲洗,再用消毒液清洗消毒后安装。每三个月一次用过氧化氢干雾对无菌室消毒(梅雨季节增加频次),对无菌室进行熏蒸,或无菌室环境发生异常情况时需熏蒸无菌室。熏蒸时应关闭净化系统,打开双向连锁门,用量为800ml过氧化氢,熏蒸45min,密闭4小时后,开启净化系统,使循环30分钟后,用消毒剂擦洗无菌室。
2.3 微生物人员控制
除实验室微生物组检测员及本部门相关管理人员外,其他人员不得随意进入洁净区。进入洁净区,操作人员必须进入指定的房间,相邻的房间不得随意进出。每个洁净区实验室内不得超过3名工作人员。一旦洁净区内的机器发生故障需要维修人员进入维修的,在不影响检验操作的情况下允许维修人员穿着无菌衣进入,但不得超过2名。所有维修工器具需放在传递窗内紫外灯下照射至少30分钟。进入无菌室操作时,必须对超净台内的环境及工作区域进行动态沉降菌监测。在超净台的左、中、右各放胰酪大豆胨琼脂平皿一个,工作区四个角及室中各放胰酪大豆胨琼脂平皿一个,打开平皿盖,暴露至无菌操作结束,盖上碟盖,倒置,同时编号。操作结束后,操作人员须进行指纹测试:打开含胰酪大豆胨琼脂培养基的平皿,分别在二个碟子内按上左右手各5个指纹,关闭平皿盖,例置。取三个胰酪大豆胨琼脂培养皿,打开碟盖,每碟粘取身上的无菌衣左臂、右臂及胸前任一个点,共取三个点,每点轻按5秒,然后闭盖,平皿倒置收起。将所有沉降菌碟及接触碟移入30~35℃培养箱内,培养72小时. 一个操作者的无菌衣的三个取样点菌落数之和≤10cfu。一个操作者的手指菌每只手≤3cfu。
2.4 AI在微生物限度和无菌操作中的应用
目前先进的制药企业已可以通过AI技术对更衣确认过程进行精准控制和比对。

人工智能(AI)在无菌操作中可以应用于以下几个方面:
无菌环境的监测:通过安装传感器和监测设备,可以收集环境参数数据,如温度、湿度、气压、气体浓度等,并利用AI技术分析这些数据,实现对无菌操作环境的实时监测和控制。
无菌操作过程中的自动化控制:利用机器学习和深度学习等AI技术,对无菌操作中的自动化设备进行优化和改进,实现无菌操作的自动化控制。例如,使用机器人进行样品处理、实验操作、无菌包装等。
污染源追踪和预警:利用AI技术,分析和识别无菌操作环境中的污染源,如微生物、异物等,并进行预警和管理。例如,通过机器视觉技术,对无菌操作环境中的微生物进行实时检测和识别。
无菌操作过程中的数据管理和分析:利用AI技术,对无菌操作过程中产生的数据进行管理和分析,以提高生产效率和产品质量。例如,通过机器学习技术,对生产过程中的数据进行分析和预测,实现生产流程的优化和改进。

总之,AI技术在无菌和微生物操作方面的应用可以帮助企业实现无菌操作的自动化、智能化和数据化管理,提高产品质量。在AI系统完善方面根据用户实际情况和异常记录,调整检测逻辑,统计哪些情况不经常发生,哪些情况容易误报,哪些情况没必要频繁检测等。
在AI模型更新方面利用新积累的数据,训练提升模型精度,更新模型。
3、调查过程具体情况分析
3.1调查中发现直接导致偏差的明确根本原因。
例如未按照SOP执行造成的污染、在取样或检验过程中使用了较差的无菌技术、已识别的实验室错误、或使用了非无菌检验材料。分离菌的鉴别和来自检验环境相同的污染之间可能有直接联系。这些情况下,检验可认为无效。如果检验无效,阶段I调查会在不进入阶段II生产调查的情况下得出结论。后续纠正无效的原始原因。
3.2 调查可能揭示了一些问题,但没有足够证据将调查结果与偏差直接关联。
例如,如果检验期间的环境监测显示有微生物,但菌种鉴定结果与样本中的污染物不同种属,实验室调查将被认定为不确定性的,没有提供足够的证据使结果无效,调查将进入阶段II生产调查。
3.3调查结果没有显示任何实验室检验异常。
整个OOS调查过程清楚地证明所有标准操作规程都遵循了,检验员具有适当的资质进行检验,所有材料、设备和检验环境认为是可信的。报告数据和所有最终结果的计算都是正确且得到确认的。因此,偏差被确认并被认为是有效的,所以调查必须进行到阶段II,以确定生产过程中使用的工艺污染源。一旦通过阶段I调查过程实验室错误被排除或不确定,调查的重点则是生产设施、人员、工艺和物料。
以上经验可以帮助实验室对微生物数据偏差进行系统性调查和解决,确保数据准确性和合规性。在实验室中,还应该建立完善的质量管理体系和质量控制程序,对微生物检测过程进行规范化管理和监控。如果微生物检验结果超限或超标的根本原因不能确定,必须提出最可能的原因。对超趋势结果进行调查可能有助于在其发展为超标结果之前识别实验室和/或生产问题。为了防止这些微生物失败的再次发生,后续必须执行CAPA计划,明确负责人将CAPA计划的进展报告给质量控制部门及其管理人员,CAPA执行后由实验室的QA人员对CAPA的后续有效性进行定期跟踪。

